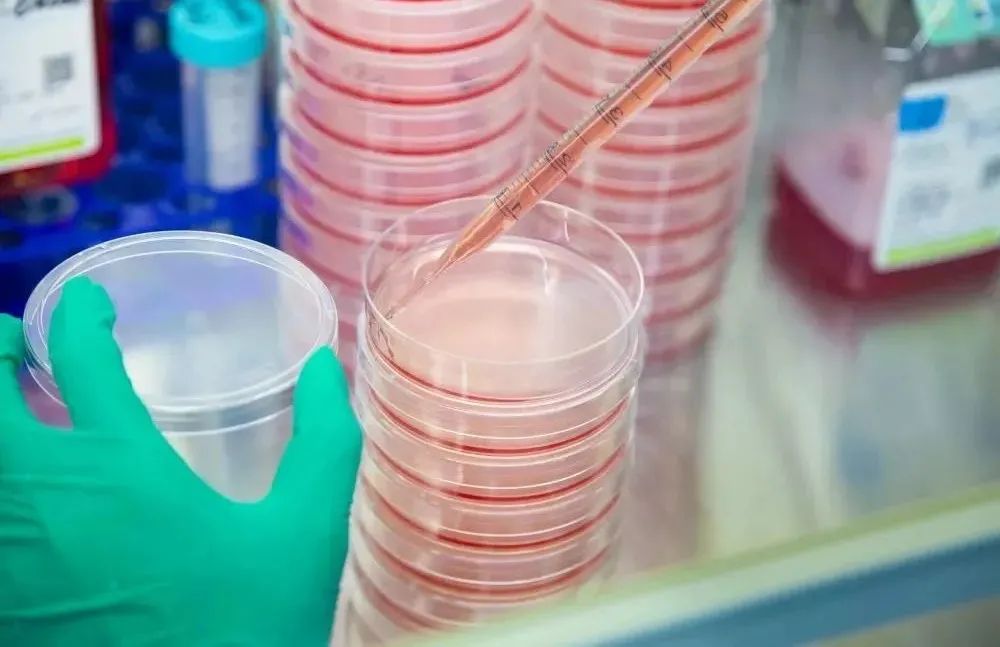

近日,国内病毒工具和病毒载体研发领域新锐企业复百澳生物完成数千万元人民币的Pre-A轮融资,本轮由嘉乐资本、领军创投联合投资。所获资金将用于公司场地扩建、新型病毒和类病毒(VLP)载体研发平台的建设。
复百澳(苏州)生物医药科技有限公司(“复百澳生物”)成立于2017年,是一家以“病毒改造技术专家”作为核心价值定位的平台型生物技术公司。自成立以来,公司已经积累了超过30余种生物医药用病毒载体的改构技术,特别在溶瘤腺病毒领域国内排名领先。
通过溶瘤病毒模块化快速构建、小规模制备和体外评价三大技术平台,成为国内为数不多的可以同时提供溶瘤腺病毒现货产品和新型溶瘤病毒产品定制服务的生物技术公司。同时,公司还借助自身技术平台和工艺开发方面的独特优势,在体外诊断(IVD)、细胞基因治疗(CGT)、动物模型构建以及疫苗等多领域提供病毒和类病毒载体产品和技术服务,并获得国内知名客户的高度认可。

病毒是一类肉眼不可见的非常细小的微生物,与人类健康息息相关。2019新冠疫情的到来表明:随着地球环境的逐步恶化、城市人口密度提高,致病性强、变异速度快的病毒成为人类健康与正常经济、社会生活的重大隐患。
因此,对病毒的检测、致病机理的研究成为一个重要方向。随着科学技术的进步,越来越多的病毒被发现并被深入研究。70余年的科学技术积累让人类得以了解并利用、改造部分病毒(形成重组病毒),使之在生物医药领域扮演了不可或缺的重要角色(如下图)。
重行业壁垒较高:病毒改造底层技术是驱动行业发展的关键
重组病毒指病毒基因组特定基因/基因座(或多个基因座)被修饰的病毒。根据应用的需要,可通过基因技术(如基因调控元件的修改、基因的敲除、基因的添加等)改变野生型病毒的复制性、致病性、靶向性等性质,保留或改变病毒某些衣壳蛋白的天然构象,或使病毒携带特定的功能性基因等等。
例如,作为工具病毒使用时,需要根据实际应用场景考虑重组病毒的安全性、复制性、结构与野生型病毒的相似性、嗜性、转导效率等等;作为终端产品使用时,重组病毒在体内的安全性是首要考虑的因素,另外病毒载体的载量、嗜性、转导效率、免疫原性、生产工艺的可行性等等也非常关键。
因此,对于不同种类病毒基因组以及其表达蛋白的结构及功能的理解是建立病毒改造技术的前提。通常对于某种病毒建立深入的理解需要耗费数十年的科学研究以及实验测试。
特别是在细胞基因治疗(CGT
)
领域,病毒改造技术是引领行业发展的底层技术,驱动新药研发管线的发展。如在CAR-T领域,从起初使用逆转录病毒RV进行CAR转导逐渐转变为使用安全性更高的第四代慢病毒(4质粒转染);在基因治疗领域,逐渐从较早使用的AAV1,2,5过渡到通过衣壳改造形成的新型血清型,以更好的解决体内预存免疫的问题、改变或优化病毒的嗜性等;在溶瘤病毒领域,更是通过病毒改造技术来降低野生型病毒的致病性、免疫原性,或增强其对于肿瘤细胞的特异性、加大载量等等。此外,基于病毒改造技术衍生出的类病毒样颗粒(VLP)技术,也将为新型疫苗及mRNA/siRNA递送提供新的解决方案。

复百澳生物是国内领先的“病毒改造技术专家”,创始人团队具备行业经验十余年,研发能力强,能针对不同应用场景开发不同病毒产品。企业累计掌握腺病毒、AAV、HPV、狂犬病毒、新城疫病毒等30余种病毒载体的改造和生产能力。
目前,公司涉足标准病毒产品和CRO服务两种模式,可提供的标准产品包括但不限于分子检测假病毒质控品、靶标蛋白VLP、造模用HBV病毒等;公司在溶瘤腺病毒CRO领域位于国内前列,依托对于溶瘤腺病毒的深入理解,进一步降低其免疫原性和肝毒性,保留及提升其溶瘤效率,为国内知名溶瘤病毒研发企业以及CDMO公司提供创新技术服务。
公司首轮融资,资金将用于公司场地扩建、新型病毒和类病毒(VLP)载体研发平台的建设。随着资本的加持和公司团队的日臻完善,复百澳生物将立足病毒工具和病毒载体领域,深耕客户需求,在IVD、CGT、药物筛选等下游应用领域中为客户解决更多的痛点问题。
复百澳生物董事长兼总经理刘骏博士表示:
随着国内外管线的推进,腺病毒将会成为溶瘤病毒的重要品种,复百澳在溶瘤腺病毒CRO领域有深厚的技术积累和广泛的客户基础。同时,复百澳在IVD、生物药领域提供高品质的工具型产品,客户复购率高,已获得客户的广泛认可。
作为复百澳生物成立以来首次融资,感谢嘉乐资本、领军创投的信任和支持。公司团队在资本的助力下,会继续专注于对病毒的前沿研究,加大研发投入、开发新的载体工具,同时扩充生产能力、持续优化团队,以更快速高效、高质量地满足下游客户的需求。通过与客户共同成长,公司将积极助推国内溶瘤病毒、重组病毒工具等产业发展,成为国内重组病毒领域的领先者。
嘉乐资本副总裁杨利华博士表示:
一直以来,我们非常认可由刘博士带领的这支充满活力、富有开拓精神的创业团队。公司团队在重组病毒领域深耕十余年,对三十余种病毒的结构和功能有深刻的理解,能够根据不同应用场景和客户需求,快速响应开发出不同的重组病毒产品。在生命科学应用场景逐步多样化的今天,病毒产品一方面以其种类的多样,成为IVD、生物药研发的重要工具,另一方面,成为CGT领域不可或缺的重要载体。
我们坚定看好具备病毒改造底层技术,并且能够针对客户痛点提供从实验室到临床前级别(IIT)病毒定制生产服务的企业。复百澳生物研发能力强、产品质量稳定且交付快,客户口碑好,相信公司会在生命健康领域会越走越长远。感谢公司在众多投资人中选择与嘉乐资本合作,相信我们双方的合作能够进一步推动公司在病毒工具领域提升核心竞争力,并促进中国的生命健康领域发展。
领军创投投资一部负责人陶珊珊表示:
生物医药是苏州工业园区重点支持和发展的行业,重组病毒作为生物医药领域不可或缺的重要工具及载体,具有广阔的发展前景。刘骏博士带领的复百澳生物团队,在重组病毒领域深耕多年,具备高品质的快速定制化服务能力。我们看好公司病毒改造的底层平台技术,希望公司立足园区,不断夯实基础,服务更多客户,成为病毒工具领域的领军企业。
嘉乐资本作为一家专注于生物医药领域的专业化基金,已经投资了包括赛普生物、东抗生物、宏韧医药等在内的多家关键上下游企业,未来会继续聚焦“生物上游卡脖子的核心生物技术”领域,做更多的投资布局。
成立于2012年12月,由苏州工业园区企业发展服务中心全资控股,注册资本3.675亿元,在管基金包括园区科创基金、领军元睿金融科技基金等,基金管理规模20亿元,是目前苏州工业园区规模最大的政策性天使投资机构,在配合园区引进高端人才、促进企业快速成长、营造科技创新生态等方面发挥了积极的作用。
由苏州工业园区财审局作为LP、领军创投作为GP共同设立。基金一期总规模15亿元,聚焦生物医药、纳米技术应用、人工智能等战略性新兴产业重点领域,采取直投和拨投结合方式,支持区内科技型、创新型企业做大做优做强。

个人中心
个人中心
 我是园区
我是园区




